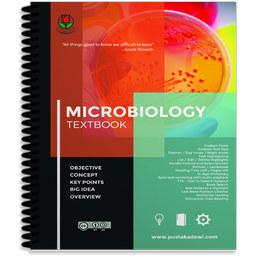

| نصب | +۱۰ |
| از ۰ رأی | ۰ |
| دستهبندی | آموزش |
| حجم | ۷۷ مگابایت |
| آخرین بروزرسانی | ۲۹ دی ۱۴۰۳ |
| نصب | +۱۰ |
| از ۰ رأی | ۰ |
| دستهبندی | آموزش |
| حجم | ۷۷ مگابایت |
| آخرین بروزرسانی | ۲۹ دی ۱۴۰۳ |
تصاویر برنامه





معرفی برنامه
A microbe, or microorganism, is a microscopic organism that comprises either a single cell (unicellular); cell clusters; or multicellular, relatively complex organisms.
The study of microorganisms is called microbiology, a subject that began with Anton van Leeuwenhoek's discovery of microorganisms in 1675, using a microscope of his own design.
Table Of Content :
1 Introduction to Microbiology
2 Chemistry
3 Microscopy
4 Cell Structure of Bacteria, Archaea, and Eukaryotes
5 Microbial Metabolism
6 Microbial Genetics
7 Microbial Evolution, Phylogeny, and Diversity
8 Viruses
9 Epidemiology
10 Immunology
11 Immunology Applications
12 Antimicrobial Drugs
13 Pathogenicity
14 Diseases
15 Microbial Ecology
16 Industrial Microbiology
The eBooks app features allows the user to :
Custom Fonts
Custom Text Size
Themes / Day mode / Night mode
Text Highlighting
List / Edit / Delete Highlights
Handle Internal and External Links
Portrait / Landscape
Reading Time Left / Pages left
In-App Dictionary
Media Overlays (Sync text rendering with audio playback)
TTS - Text to Speech Support
Book Search
Add Notes to a Highlight
Last Read Position Listener
Horizontal reading
Distraction Free Reading
Credits :
Boundless (Creative Commons Attribution-ShareAlike 3.0 Unported (CC BY-SA 3.0))
FolioReader, Heberti Almeida (CodeToArt Technology)
Cover by Designed by new7ducks / Freepik
Pustaka Dewi, www.pustakadewi.com
برنامههای مرتبط










دیگران نصب کردهاند




















